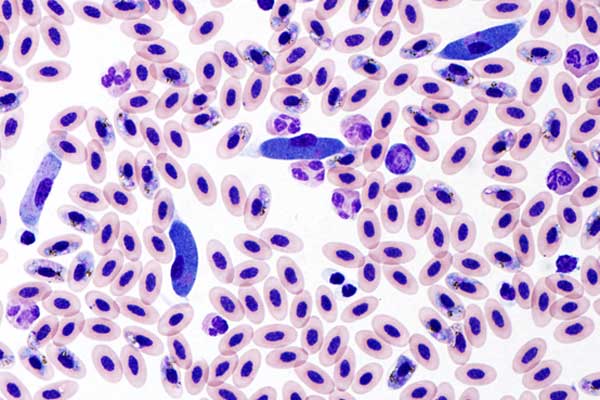
Veterinary Pathology under a microscope

Program
Advance your career as a veterinary pathologist with a tailored, year-long graduate certificate that immerses you in real-world diagnostic investigations. Train alongside highly qualified diagnostic pathologists and build the expertise to solve complex disease problems and prepare for American College of Veterinary Pathologists (ACVP) certification.
Why choose USask for Veterinary Diagnostic Pathology?
- Direct, high-volume diagnostic experience through Prairie Diagnostic Services, Inc., the Canadian Wildlife Health Cooperative, the Animal Health Centre in British Columbia, and other leading Canadian veterinary laboratories.
- A highly customizable year of advanced training designed to strengthen readiness for ACVP certification through mentorship, teaching experience, and intensive study.
Quick facts
-
Expected length Thesis-based Course-based G.Cert. 1 year - Certificate requirements
- Class delivery in-person
- Supervisor not applicable
- Deadlines and admission details below
Defenders of animal health
Gain advanced diagnostic skills that help protect animal populations and strengthen the quality of veterinary diagnostic services.
Graduate Certificate in Veterinary Diagnostic Pathology

This year-long certificate provides veterinarians with prior training in pathology the opportunity to deepen their diagnostic expertise through an intensive, practice-focused program. Students complete a single, nine-credit course—Advanced Veterinary Diagnostic Pathology—that spans three consecutive terms and is customized to their professional goals.
Throughout the program, you will gain significant exposure to the day-to-day work of veterinary diagnostic pathology. Depending on your training plan, your experience may include:
- participating in diagnostic case investigations through approved diagnostic laboratories
- contributing to teaching activities, such as supervising junior trainees and assisting with lectures or laboratories for undergraduate veterinary students
- engaging in research or scholarly work aligned with your interests and advisory committee guidance
- presenting within departmental seminar series and attending relevant national or international meetings or conferences
- completing structured self-directed study, including materials recommended in ACVP reading lists, to support advanced competency development
The program typically runs from mid-August to mid-August. Of the 52-week cycle, approximately 48 weeks are dedicated to academic and diagnostic activities, evenly divided between hands-on diagnostic service/teaching and additional diagnostic work, research, scholarly activity, or intensive study.
Designed for motivated veterinarians seeking advanced professional growth, the certificate provides a robust foundation for those preparing to sit the American College of Veterinary Pathologists (ACVP) certifying examination or pursuing further specialized training.
Tuition and funding
Funding
Applicants who are graduates of a recognized program of veterinary medicine and Canadian citizens or permanent residents may be eligible for financial support from the WCVM Interprovincial Graduate Fellowship fund on a competitive basis.
Tuition and fees
Course-based master's, certificate or postgraduate diploma program
Students in course-based programs pay tuition for each class they take. Every class is assigned a number of credit units (usually three) which determines their cost. If a student is not enrolled in any classes for a term, they will need to register in a 'Maintenance of Status' class that is assessed tuition equivalent to 3 credit units to stay in their program.
| Canadian students | International students | |
|---|---|---|
| Maintenance of Status course | ||
| Cost per graduate credit unit | ||
| Cost per 3 credit unit graduate class |
Student fees
In addition to tuition above, students also pay fees for programs like health and dental insurance, a bus pass, and other campus services. The amount you need to pay depends on if you are taking classes full time or part time, and if you are on campus or not. The table below assumes you are on campus full-time.
| Fall 2025 | Winter 2026 | Spring 2026 | Summer 2026 | |
|---|---|---|---|---|
| Student fees | $578.45 CAD | $804.73 CAD | $36.75 CAD | $36.75 CAD |
Tuition information is accurate for the current academic year and does not include student fees. For detailed tuition and fees information, visit the official tuition website.
View 2026-2027 tuition and fees rates through the financial planning estimator tool. By June, tuition information on this website will be updated with 2026-2027 tuition and fee information.
Admission requirements
Graduate Certificate (G.Cert.)
To be accepted into the CVDP program, applicants must:
- be a graduate of a recognized program of veterinary medicine and, therefore, have earned a DVM degree or equivalent;
- in addition to a D.V.M., must have a minimum of 2 years of additional, recognized post-D.V.M. veterinary diagnostic pathology training and have demonstrated competence;
- possess a weighted average of at least 75% (USask grade equivalencies) during their veterinary diagnostic pathology training program, if applicable (as not all veterinary diagnostic pathology training programs, or residencies, use grades);
- arrange for the submission of 3 strong letters of reference that predict success in a busy veterinary diagnostic pathology training program;
- provide evidence, if necessary, of proficiency in English consistent with that required by the CGPS; and,
- be eligible for licensure by the Saskatchewan Veterinary Medical Association.
Application process and deadlines
Deadlines and important dates
| Start term | Application deadline |
|---|---|
| Fall term | October 15 |
Submit an online application
International students - Master's and doctoral students applying for a study permit do not need a Provincial Attestation Letter (PAL). Certificate and Postgraduate Diploma students, as well as Visiting Research students studying over six months, still need a PAL. Review federal international study permit policies before you apply.
Before beginning your online application, be sure that you have carefully reviewed all program information and admission requirements on this page.
During the application, you'll be asked for:
- Personal information such as your name, address, etc.
- Contact information of your three referees
- For your letters of recommendation, two of your referees must be academic contacts, and the third may be academic or professional
- Your complete academic history from all previous post-secondary institutions
The application takes about 30 minutes to complete. You may save your application and return to it later.
At the end of the application, you will need to pay a non-refundable application fee: $125 for domestic students and $145 for international students. Your application will not be processed until payment is received.
Submit required documents
Once you've submitted your online application, you will have access to upload your required documents, and provide the contact information for your references. To do this, go to the "Supplemental Items & Documents" tab in your application.
Preliminary Statement of Marks
- Once you have submitted your application for admission and paid the application fee, you will be required to upload unofficial PDF copies of your academic transcript(s) from each post-secondary institution attended. This requirement will appear as Preliminary Statement of Marks or Additional Prelim. Statement under admission requirements on your Application Summary when you check your application status.
- The uploaded transcript can be an unofficial copy of the transcript issued by the university or college and must include a grading key/legend.
- All pages of a transcript must be uploaded as a single PDF document.
- Uploaded transcripts will be considered unofficial or preliminary. Official copies of your transcripts will be required only for applicants offered admission. This requirement will appear as Post-secondary Transcript under admission requirements on your Application Summary when you check your application status.
- Transcripts in languages other than English must be accompanied by a certified translation.
For students who are required to provide proof of English proficiency:
- Completing a relevant test with the appropriate score is required before the application deadline.
- Tests are valid for 24 months after the testing date and must be valid at the beginning of the student's first term of registration in the graduate program.
- Applicants will be required to upload a PDF copy of any required language test score. Uploaded test scores will be considered unofficial or preliminary.
- Letter of intent
- Current curriculum vitae
- Transcripts from veterinary diagnostic training program
- Names and contact information for 3 people willing to provide letters of reference
- Identify a source of personal funding during the CVDP program
Contact
Department of Veterinary Pathology
52 Campus Drive
University of Saskatchewan
Saskatoon, SK S7N 5B4
Graduate Chair
Dr. Susan Detmer
Email: susan.detmer@usask.ca
Graduate Program Coordinator
Angela Turner
Email: angela.turner@usask.ca
- Department of Veterinary Pathology
Learn more about the academic unit offering this program - Program and Course Catalogue
To view official admission and program requirements

